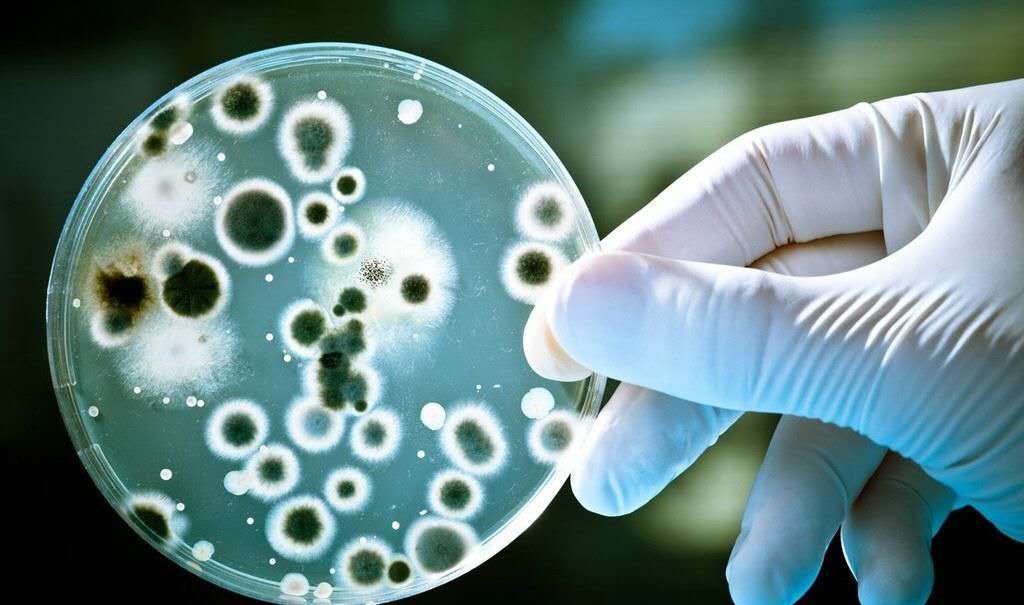
洗衣机洗的衣服有臭味,衣服阴干后有味怎么处理

大家好,欢迎来到“氯化钠NaCl”,这里每天都会分享一些科普小知识,喜欢的朋友请关注。
平时大家洗完衣服之后,衣服总是会散发出淡淡的香味。但是,如果遇到了阴雨天气,刚洗完的衣服就要“遭殃”了。因为衣服在阴干的情况下特别容易发臭,这种臭味相信也很少有人能忍受。没及时晾干散发出的“臭脚味”是怎么形成的呢?可能是由于以下两种原因:
一、衣服长时间晾在阳台,导致细菌滋生使衣服变臭。

春天潮湿温暖的天气有利于细菌的繁殖,在这种适宜生存的环境下,没晾干的衣服简直就是细菌生长和繁殖的天堂。因为衣服没有晾干,就会使得人们把衣服晾得更久,细菌滋生,代谢的产物越积越多,衣服就变得越来越臭了。

解决办法:细菌滋生的臭味非常接近死鱼和臭脚的味道,相信你也一定接受不了这种臭味。如果我们继续把衣服晾着,一直等到晴朗的天气再拿出来晾晒的话也只是能淡化其中的味道,并不能完全去除臭味。如果遇到这种情况当然是再洗一遍除臭的效果会更好,可以等到一个晴朗些的天气,在进行统一清洗,并进行晾晒,这样才能完全把臭味完全去除。否则无论怎么做,衣服也总会残留一些臭味。把衣服重新洗一遍也许是最卫生的办法了。

二、误以为衣服干了,把湿的衣服收进衣柜培养了细菌。

阴雨天气洗衣服了,空气也是潮湿的,当人们收衣服的时候,手的触感形成了错觉,导致以为衣服是干的,其实此时的衣服并没有完全干透。这时候就把衣服放进衣柜里,几天过后想把衣服拿出来穿,结果发现衣服是臭的,其实这也是因为滋生了细菌。空气里悬浮细菌的芽孢,这些芽孢通过衣服被带进衣柜里,在衣柜潮湿和较温暖的环境下,非常有利于细菌的繁殖,衣服同样是被细菌的代谢产物所污染,就变臭了。
解决办法:在阴雨天气收衣服的情况下,可以使用吹风筒进一步将衣物吹干,待衣服变得更干后再放入衣柜中就能防止变臭了。如果还不放心,可以在衣柜内增添一些干燥剂或者除湿盒,以保证衣服处在一个干燥的环境中。

除湿盒
细菌的滋生也需要一定的条件和时间,当然家里有烘干机把衣服及时烘干是最好的了。但是,如果家里的衣服真的因为没晾干而变臭了,希望以上的两个方法能帮助到大家。
想了解更多科普小知识,欢迎关注“氯化钠NaCl”